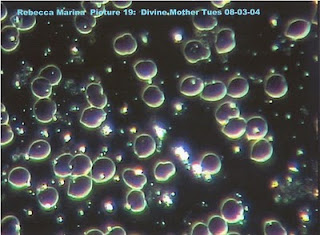

Sebelum melakukan EFT ( sel darah merah menggumpal disebabkan oleh Lectin yang didapat dari alergi ayam & alpukat )
Sesudah melakukan EFT ( sel darah merah menjadi normal kembali )
Kemudian Rebecca melakukan EFT lagi dan mengundang emosi “sedih” dengan cara memikirkan saat-saat sedih sampai dia menangis, lalu sang pakar EFT ( Dr. Felicy) mengambil sampel darahnya lagi.
Kondisi darah saat sedih ( sel darah begerak cepat dan berbentuk air mata ). Lalu Rebecca menggunakan EFT untuk mengundang energi “cinta” untuk memasuki tubuh dan darahnya. Dan seketika darahnya kembali normal, dan sel-sel darah bergerak dengan indah dan timbul substansi yang berkilauan dalam cairan darah.
Kondisi darah saat merasakan cinta : ( sel darah bergerak pelan dan cenderung berkumpul )
Satu kenyataan menarik pada sampel darah saat “sedih” terjadi perubahan seperti pada sampel darah saat “merasakan cinta”. Jadi walaupun darah itu sudah meninggalkan tubuh Rebecca ia tetap masih berhubungan dengan pemiliknya.
Kemudian seorang Rebecca mengundang rasa takut dan memikirkan kejadian menakutkan yang pernah ia alami. Dan sel-sel dalam darahnya bergerak tidak beraturan dengan sangat cepat (ditunjukkan pada gambar dibawah dimana terlihat sel-sel darah saling berjatuhan). Mungkin ini adalah akibat dari produksi adrenalin sebagai reaksi normal atas rasa takut.
Kemudian seorang Rebecca mengundang rasa takut dan memikirkan kejadian menakutkan yang pernah ia alami. Dan sel-sel dalam darahnya bergerak tidak beraturan dengan sangat cepat (ditunjukkan pada gambar dibawah dimana terlihat sel-sel darah saling berjatuhan). Mungkin ini adalah akibat dari produksi adrenalin sebagai reaksi normal atas rasa takut.
Kondisi darah saat merasa takut
Lalu Rebecca mecoba untuk memikirkan “sifat feminine Tuhan”. Dalam keyakinan agamanya ia sebut “divine mother”, sifat penyayang, penyantun dan pemelihara ( dalam islam disebut sifat “Jamaliah” Allah). Dan memohon kepada-Nya untuk menyalurkan energi feminine itu kedalam tubuh dan darahnya. Saat berdoa tersebut, Rebecca merasakan seperti ini “saya merasakan gelombang energi yang begitu besarnya menyelimuti diri saya, saya sampai menangis bahagia karenanya”, begitu Rebecca tersebut menggambarkan pengalamannya.
Saat sampel darah Rebecca diambil setelah berdoa dan merasakan pengalaman religius itu, kemudian dilihatkan dibawah mikroskop yang dihubungkan dengan komputer, semua yang hadir dilaboratorium itu seketika terdiam dan terpana karena melihat komdisi darah yang sama sekali berbeda dengan yang lain, cairah darahnya sangat cerah, gerakan sel darah sangat tenang seakan bergerak dengan penuh kedamaian, muncul banyak substansi yang berkilauan. Di dalam sel darah terdapat substansi yang bercahaya dan berdenyut seperti denyutan jantung mini.
Kondisi darah saat "berdo’a" (timbul substansi putih berkilauan dan darah bergerak pelan dan sangat teratur).Lalu Rebecca mecoba untuk memikirkan “sifat feminine Tuhan”. Dalam keyakinan agamanya ia sebut “divine mother”, sifat penyayang, penyantun dan pemelihara ( dalam islam disebut sifat “Jamaliah” Allah). Dan memohon kepada-Nya untuk menyalurkan energi feminine itu kedalam tubuh dan darahnya. Saat berdoa tersebut, Rebecca merasakan seperti ini “saya merasakan gelombang energi yang begitu besarnya menyelimuti diri saya, saya sampai menangis bahagia karenanya”, begitu Rebecca tersebut menggambarkan pengalamannya.
Saat sampel darah Rebecca diambil setelah berdoa dan merasakan pengalaman religius itu, kemudian dilihatkan dibawah mikroskop yang dihubungkan dengan komputer, semua yang hadir dilaboratorium itu seketika terdiam dan terpana karena melihat komdisi darah yang sama sekali berbeda dengan yang lain, cairah darahnya sangat cerah, gerakan sel darah sangat tenang seakan bergerak dengan penuh kedamaian, muncul banyak substansi yang berkilauan. Di dalam sel darah terdapat substansi yang bercahaya dan berdenyut seperti denyutan jantung mini.

Tidak ada komentar:
Posting Komentar
Saran & Kritik yg Membangun... OK!